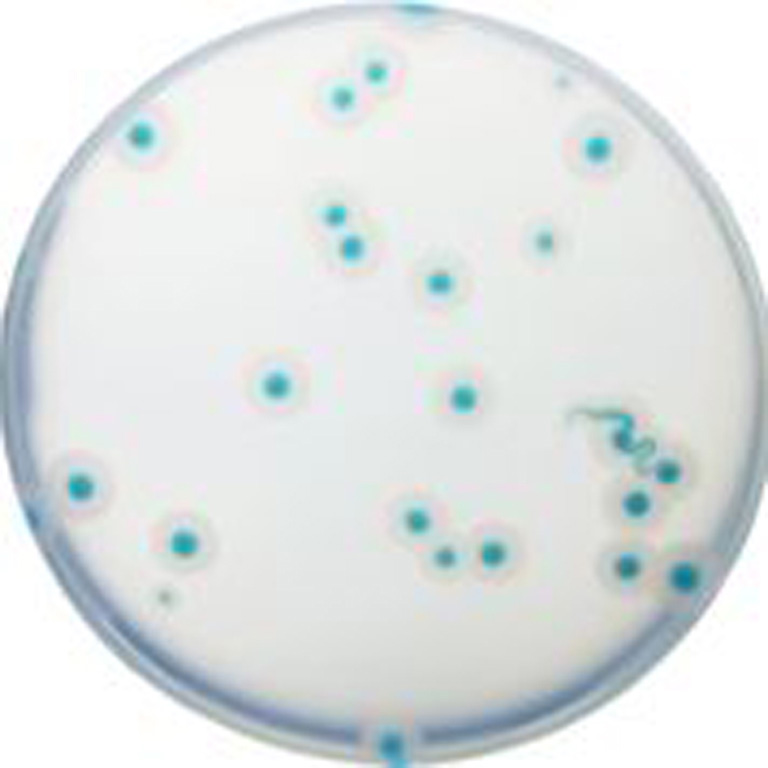

Über das Produkt
Chromogenes Medium zum Nachweis und zur Zählung von Erregern der Bacillus cereus-Gruppe in Umwelt- und Lebensmittelproben.
CHROMagar B.cereus (5L) - ohne CE
Chromogenes Medium zum Nachweis und zur Zählung von Erregern der Bacillus cereus-Gruppe in Umwelt- und Lebensmittelproben.